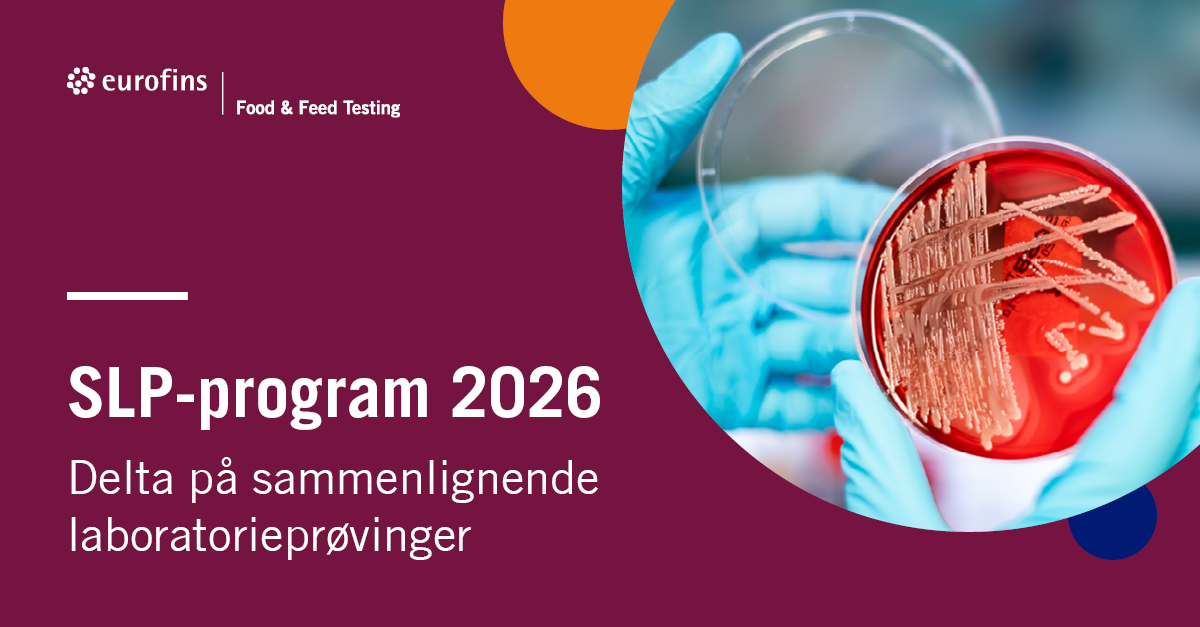
SLP-program 2025

Det er på tide å planlegge din deltakelse i SLP for 2026

Sammenlignende laboratorieprøvinger (SLP) er en viktig del av laboratoriets kvalitetssikring av analyseresultater. Dette gir en objektiv vurdering av laboratoriets prestasjon samtidig som det gir en unik mulighet til kompetanseheving.
Eurofins Food & Feed Testing Norway AS tilbyr SLP innen mikrobiologi, både for næringsmidler, vann og hygiene (miljøprøver). Vi er de eneste i Norge som tilbyr dette akkreditert etter NS – EN ISO 17043 innen mikrobiologi. Alle laboratorier som tilbyr sine analyser akkreditert etter NS – EN ISO 17025, må delta i SLP, der det er tilgjengelig. Hvis du ikke selv representerer et laboratorium, spør det laboratoriet som du anvender til dine analyser, om de deltar i SLP!